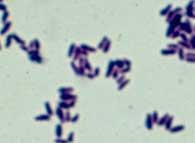
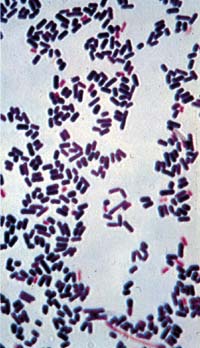

Yesterday: muscle aches, nausea and diarrhea
Today: headache, stiff neck, confusion, loss of balance, fever
Symptoms:
Three days ago I had a little papule (pimple) on my skin. Yesterday it got worse and turned into a painful ulcer. Today it looks black in places. I also have some pain in my lymph nodes and a fever

Lab culture:
Yesterday I started experiencing general malaise and sore throat

Gram stain:
Symptoms: I have these skin sores. My doc at the farm fixed me up already. Funny thing is, I can’t feel anything in my hand.

Laboratory tests:

Symptoms:
My foot really hurts. It’s got these air-filled blisters all over it.



Symptoms: I am sweating, low blood pressure, difficulty swallowing, drooling, jaw muscles and facial muscles contracted


Symptoms: Diarrhea, cramps, nausea started 3 hours ago.

Symptoms: Sore on face


Symptoms: Constant diarrhea starting 3 days ago
If examined: colonic mucosa is damaged and has a pseudomembrane covering it

Laboratory culture:

Symptoms: multiple inflammatory follicular lesions on the face. Some are pus-filled. These have been around for 5 years but got worse in the last month.


Symptoms: weakness, dizziness, blurred vision, dry mouth, constipation, abdominal pain
Laboratory tests:
Symptoms: malaise, night sweats, weight loss, cough
Laboratory tests:

Microscopy:

PPT Skin test

Symptoms: purplish inflammatory lesion spreading outward on hand. lesion is painful but no pus.
